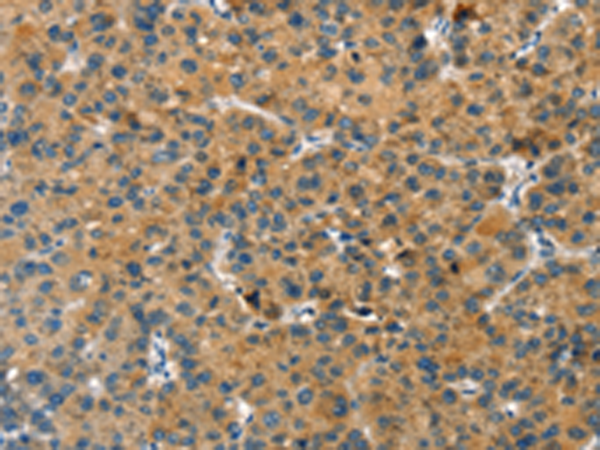
一抗

中文名稱:兔抗RACK1多克隆抗體
英文名稱: Anti-RACK1 rabbit polyclonal antibody
別 名: receptor for activated C kinase 1; H12.3; HLC-7; P
相關(guān)類別: 一抗
儲 存: 冷凍(-20℃)
宿 主: Rabbit
抗 原: RACK1
反應(yīng)種屬: Human, Mouse, Rat
標(biāo)記物: Unconjugate
克隆類型: rabbit polyclonal
技術(shù)規(guī)格
|
Background: |
Scaffolding protein involved in the recruitment, assembly and/or regulation of a variety of signaling molecules. Interacts with a wide variety of proteins and plays a role in many cellular processes. Component of the 40S ribosomal subunit involved in translational repression (PubMed:23636399). Involved in the initiation of the ribosome quality control (RQC), a pathway that takes place when a ribosome has stalled during translation, by promoting ubiquitination of a subset of 40S ribosomal subunits (PubMed:28132843). Binds to and stabilizes activated protein kinase C (PKC), increasing PKC-mediated phosphorylation. May recruit activated PKC to the ribosome, leading to phosphorylation of EIF6. Inhibits the activity of SRC kinases including SRC, LCK and YES1. Inhibits cell growth by prolonging the G0/G1 phase of the cell cycle. Enhances phosphorylation of BMAL1 by PRKCA and inhibits transcriptional activity of the BMAL1-CLOCK heterodimer. Facilitates ligand-independent nuclear translocation of AR following PKC activation, represses AR transactivation activity and is required for phosphorylation of AR by SRC. Modulates IGF1R-dependent integrin signaling and promotes cell spreading and contact with the extracellular matrix. Involved in PKC-dependent translocation of ADAM12 to the cell membrane. Promotes the ubiquitination and proteasome-mediated degradation of proteins such as CLEC1B and HIF1A. Required for VANGL2 membrane localization, inhibits Wnt signaling, and regulates cellular polarization and oriented cell division during gastrulation. Required for PTK2/FAK1 phosphorylation and dephosphorylation. Regulates internalization of the muscarinic receptor CHRM2. Promotes apoptosis by increasing oligomerization of BAX and disrupting the interaction of BAX with the anti-apoptotic factor BCL2L. Inhibits TRPM6 channel activity. Regulates cell surface expression of some GPCRs such as TBXA2R. Plays a role in regulation of FLT1-mediated cell migration. Involved in the transport of ABCB4 from the Golgi to the apical bile canalicular membrane (PubMed:19674157). Promotes migration of breast carcinoma cells by binding to and activating RHOA (PubMed:20499158). |
|
Applications: |
ELISA, WB, IHC |
|
Name of antibody: |
RACK1 |
|
Immunogen: |
Fusion protein of human RACK1 |
|
Full name: |
receptor for activated C kinase 1 |
|
Synonyms: |
H12.3; HLC-7; PIG21; GNB2L1; Gnb2-rs1 |
|
SwissProt: |
P63244 |
|
IHC positive control: |
Human liver cancer and Human brain |
|
IHC Recommend dilution: |
25-100 |
|
WB Predicted band size: |
35 kDa |
|
WB Positive control: |
Hepg2, NIH/3T3 and Jurkat cells |
|
WB Recommended dilution: |
500-2000 |


 購物車
購物車 幫助
幫助
 021-54845833/15800441009
021-54845833/15800441009